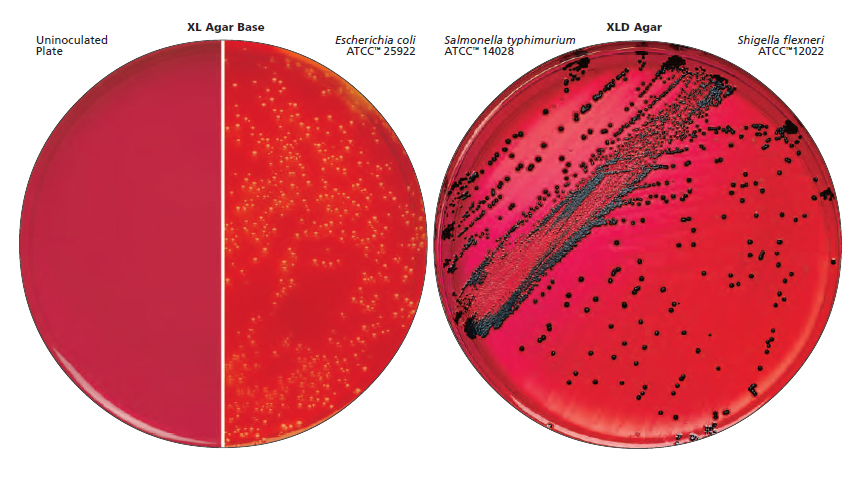

용도
XL (Xylose Lysine) Agar Base는 장내 병원체의 분리 및 구별에 사용되며 적절한 첨가물로 보충되면 선택적인 장내 미생물 배지의 기본으로 사용됩니다. XLD Agar는 완전한 Xylose Lysine Desoxycholate Agar로, 특히 시게라 종에 대한 분리 및 구별을 위해 권장되는 중간적인 선별 배지입니다. XLD Agar는 미국 의약규격 (USP), 유럽 의약규격 (EP) 및 일본 의약규격 (JP)의 성능 규격을 충족합니다.
요약 및 설명
다양한 배지가 개발되어 장내 병원체의 선택적 분리 및 구별을 돕기 위해 사용되고 있습니다. 다양한 영양 요구 및 화학적 저항성 패턴을 가진 다양한 미생물 종 및 균주로 인해 연구원들은 미생물의 분리 및 식별에 관한 일반 및 특수한 요구 사항을 충족시키기 위해 다양한 조성을 개발해 왔습니다. XL Agar Base는 Taylor에 의해 만들어진 것으로, 음극성 장내 배양균의 비선택적인 분리 및 구별을 위해 권장되며, 특히 장내 미생물의 수를 확인하는데 적합합니다. 이 매체는 Sodium desoxycholate(2.5 g/L)를 첨가하여 장내 병원체, 특히 시게라에 대해 중간 정도로 선택적으로 만들 수 있습니다. XL Agar Base는 고압 멸균 전에 기존 배지에 1%의 수용성 브릴리언트 그린(1.25 mL/L)을 첨가함으로써 살모넬라에게 선택적으로 만들 수 있습니다. 이것은 음식 분석에서 셀레나이트 또는 테트라티온 확대 후 살모넬라 분리에 권장됩니다. 둘 다 대장균과 시게라를 억제시킵니다. Taylor에 의해 개발된 XLD Agar는 특히 시게라를 중심으로 장내 병원체의 분리 및 식별의 효율성을 높이기 위해 만들어졌습니다. 병원체는 비병원성 락토스 발효균과 다르게 락토스 또는 슈크로스를 발효하지 않는 다양한 비병원성 균으로부터 구별됩니다. 게다가, 이 매체는 과도하게 독성을 가진 억제제를 포함하여 다른 조성물에서 종종 성장하지 못한 미생물의 성장 빈도를 증가시키기 위해 조성되었습니다. 임상 평가에서 얻은 결과는 XLD Agar의 상대적으로 높은 시게라 및 살모넬라의 일차 분리 효율을 지지하고 있습니다. XLD Agar는 임상 검체에서 장내 병원체를 분리 및 구별하기 위해 사용되는 선택적 및 차별적인 매체입니다. XLD Agar의 임상 실험실에서의 가치는 매체가 특히 시게라와 같은 섬세한 장내 미생물을 지원하는데 더 효과적이기 때문입니다. 또한 XLD Agar는 다양한 산업 표준 시험 방법에서 음식, 유제품 및 물의 테스트에 권장됩니다. 미국 의약규격의 일반 장 <62>은 XLD Agar를 고체 배양 배지로 사용하여 비살균 의약품에서 살모넬라를 분리하기 위한 시험 방법을 기술하고 있습니다.
원리
자일로스는 실제로 시게라를 제외한 거의 모든 장내 균에 의해 발효되기 때문에 매체에 포함되어 있습니다. 이 특성은 시게라 종을 구별할 수 있게 합니다. 리신은 살모넬라 그룹이 비병원성 균과 구별될 수 있도록 포함되었습니다. 리신이 없으면 살모넬라는 빠르게 자일로스를 발효하고 비병원성 종과 구별할 수 없게 됩니다. 살모넬라가 자일로스의 공급을 고갈시킨 후 리신은 리신 탈탄소화효소를 통해 공격받아 알칼리성 pH로 변화하며 시게라 반응을 모방합니다. 리신 양성 대장균이 유사한 역전되는 것을 방지하기 위해 락토스와 슈크로스(사크로스)가 과다한 산을 생성하도록 첨가됩니다. 자일로스, 락토스 및 슈크로스의 분해로 인해 산 생성물이 발생하며 pH 지시제 페놀 레드의 존재하에서 매체의 색상이 빨간색에서 노란색으로 변화합니다.
https://sejinscience.com/goods/search?osearchtext=278850
세진과학 종로3가
실험실에서 사용하시는 모든 제품을 공급해 드리고 있습니다.
sejinscience.com
'BD Difco' 카테고리의 다른 글
| BD Difco 211825 Bacto™ Tryptic Soy Broth/Trypticase™ Soy Broth(Soybean-Casein Digest Medium) (0) | 2024.02.08 |
|---|---|
| BD Difco 271210 YM Agar • 271120 YM Broth (0) | 2024.02.06 |
| BD Difco/Gibco 212750 Bacto™ Yeast Extract (0) | 2024.02.01 |
| BD Difco 291940 Yeast Nitrogen Base without Amino Acids (1) | 2024.01.31 |
| Yeast Extract-Peptone-Dextrose (YPD), Agar Yeast Extract-Peptone-Dextrose (YPD) Broth (0) | 2024.01.29 |